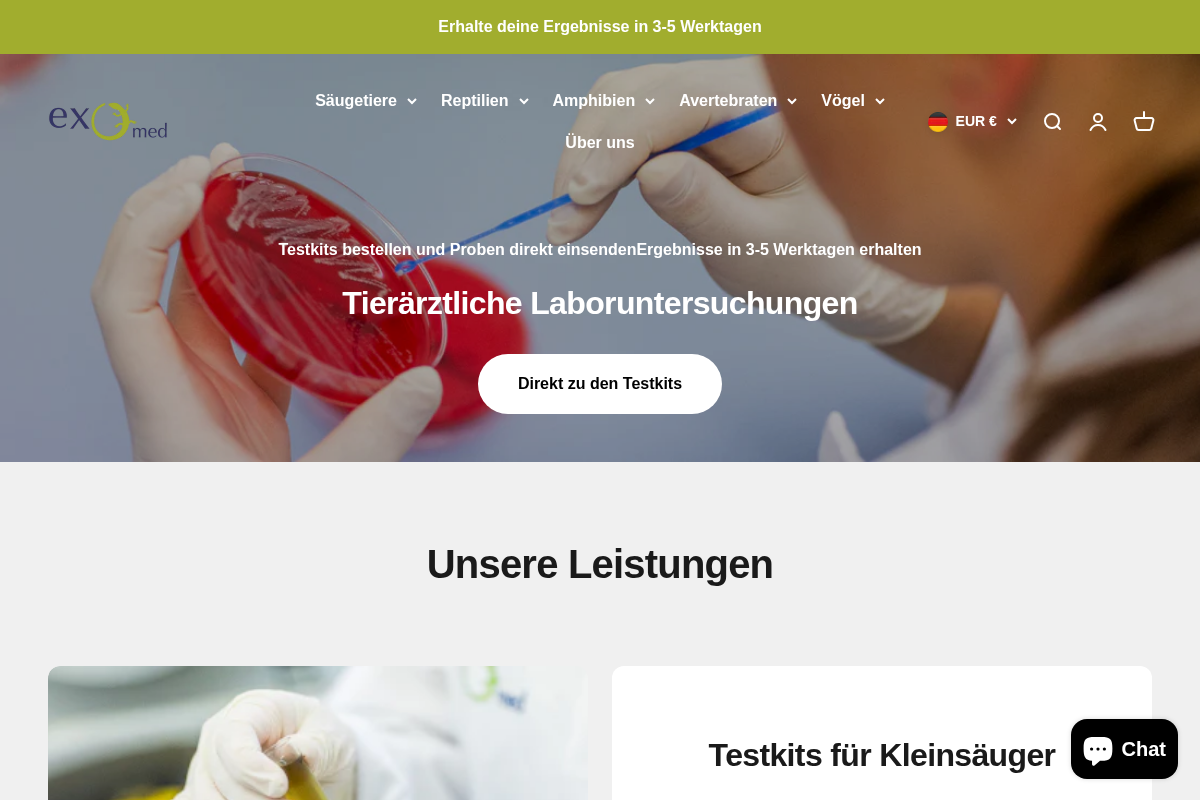
exomed homepage screenshot

Best Selling Products
 #1
#1exomed Kotuntersuchung - Nachweis von Parasiten bei Haustieren
$39.99
 #2
#2exomed Kotuntersuchung - Darmparasiten inkl. Kryptosporidien
$69.99
 #3
#3exomed Kotuntersuchung - Darmparasiten inkl. Giardien
$67.99
 #4
#4exomed Testkit - Amphibien - Chytridpilz (BD)
$66.99
 #5
#5exomed Testkit - Amphibien-Hautprofil-Haut (Bakterien/Pilze/Bd)
$139.99
 #6
#6exomed Kotuntersuchung - Kleinsäugerprofil
$154.99
 #7
#7exomed Kotuntersuchung - Fleischfresser-Profil (Hunde/Katzen)
$87.99
 #8
#8exomed Kotuntersuchung - Großtierprofil
$57.99
 #9
#9exomed Kotuntersuchung - Nachweis von Parasiten bei Großtieren
$34.99
 #10
#10Kotröhrchen 5er Pack
$9.99
Showing top 10 of 13 best sellers